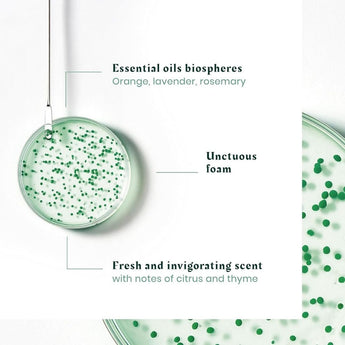

54 Produits
Soins du cuir chevelu - Anti-Pelliculaire
La collection de soins capillaires anti-pellicule et de soins du cuir chevelu d'Éléganza offre une gamme complète de produits conçus spécifiquement pour combattre les pellicules tout en apaisant et en revitalisant le cuir chevelu. Chaque produit de notre collection a été soigneusement sélectionné pour ses ingrédients actifs, qui travaillent ensemble pour éliminer les pellicules, réduire les démangeaisons et promouvoir un cuir chevelu sain. Enrichis d'extraits naturels et de technologies avancées, nos shampoings, masques et traitements ciblés purifient en douceur le cuir chevelu, rééquilibrant son hydratation et sa santé. Parfait pour tous ceux qui cherchent à restaurer l'équilibre naturel de leur cuir chevelu et à dire adieu aux pellicules une bonne fois pour toutes.